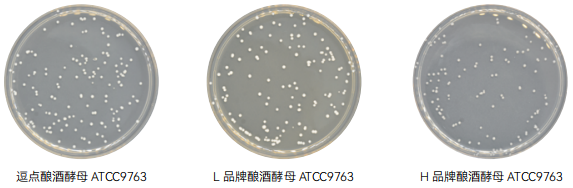
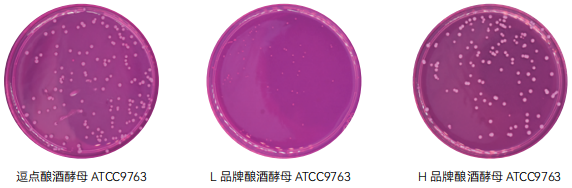

所有生物垃圾应经 121℃高压灭菌 30min 后,方可运离实验室。
3 检验程序
按下图霉菌和酵母的平板计数法的检验程序进行食品中霉菌和酵母的计数。
3.1 样品的稀释
3.1.1 固体和半固体样品
用天平无菌称取 25g±0.1g 样品。如使用锥形瓶或试管或三角瓶中,则将已称取的样品置于有 225mL 无菌稀释液的锥形瓶或试管或三角瓶中,无菌稀释液可以根据实际情况选择蒸馏水或生理盐水或磷酸盐缓冲液,充分振摇,即为 1:10 稀释液。如使用均质袋,则将已称取的样品放入盛有 225mL 无菌稀释液的均质袋中,用拍击式均质器拍打 1-2 分钟,制成 1:10 的样品匀液。
3.1.2 液体样品
以无菌吸管吸取 25mL 样品。如使用锥形瓶或试管或三角瓶中,则将已量取的样品置于有 225mL 无菌稀释液的锥形瓶或盐水罐中,无菌稀释液可以根据实际情况选择蒸馏水或生理盐水或磷酸盐缓冲液,充分混匀,即为 1:10 的样品匀液。如使用均质袋,则将已量取的样品放入盛有 225mL 无菌稀释液的均质袋中,用拍击式均质器拍打 1-2分钟,制成 1:10 的样品匀液。
3.1.3 取 1mL 1:10 样品匀液注入含有 9mL 无菌稀释液的试管中,并换一支 1mL 无菌吸管反复吹吸,或在涡旋混合器上混匀,此液为 1:100 的样品匀液。制备 10 倍递增系列稀释样品匀液,每递增稀释一次,换用一次 1mL无菌吸管。根据对样品污染状况的估计,选择 2 个~ 3 个适宜稀释度的样品匀液(液体样品可包括原液),在进行10 倍递增稀释的同时,每个稀释度分别吸取 1mL 样品匀液加入 2 个无菌平皿内。同时分别取 1mL 无菌稀释液加入 2 个无菌平皿做空白对照。
3.1.4 可提前将制备好的培养基放置于 46℃±1℃恒温水浴箱中保温,或及时将 20mL ~ 25mL 冷却至 46℃的马铃薯葡萄糖琼脂或孟加拉红培养基倾注到平皿中。转动平皿使其混合均匀,置水平台面待培养基完全凝固。
3.2 培养
琼脂凝固后,正置平板,置 28℃±1℃培养箱中培养,观察并记录培养至第 5 天的结果。
3.3 菌落计数
首先用肉眼观察,必要时可用放大镜或低倍镜,记录稀释倍数和相应的霉菌和酵母菌落数。以菌落形成单位 CFU表示。选取菌落数在 10CFU ~ 150CFU 的平板,根据菌落形态分别计数霉菌和酵母菌落数。霉菌蔓延生长覆盖整个平板的可记录为菌落蔓延。
4 结果报告
4.1 计算同一个稀释度的两个平板菌落数的平均值,再将平均值乘以相应稀释倍数计算;
4.2 若有两个稀释度平板上菌落数均在 10CFU ~ 150CFU 之间,则按照 GB 4789.2 的相应规定进行计算;
4.3 若所有平板上菌落数均大于 150CFU,则对稀释度最高的平板进行计数,其他平板可记录为多不可计,结果按平均菌落数乘以最高稀释倍数计算;
4.4 若所有平板上的菌落数均小于 10CFU,则应按稀释度最低的平均菌落数乘以稀释倍数计算;
4.5 若所有稀释度(包括液体样品原液)平板均无菌落生长,则以小于 1 乘以最低稀释倍数计算;
4.6 若所有稀释度的平板菌落数均不在 10CFU ~ 150CFU 之间,其中一部分小于 10CFU 或大于 150CFU 时,则以最接近 10CFU 或 150CFU 的平均菌落数乘以稀释倍数计算;
4.7 菌落数按 “四舍五入” 原则修约。菌落数在 10 以内时,采用一位有效数字报告;菌落数在 10 ~ 100 之间时,采用两位有效数字报告。
4.8 菌落数大于或等于 100 时,前 3 位数字采用“四舍五入”原则修约后,取前 2 位数字,后面用 0 代替位数来表示结果,也可用 10 的指数形式来表示,此时也按 “四舍五入” 原则修约,采用两位有效数字;
4.9 若空白对照平板上有菌落出现,则此次检验结果无效;
4.10 称重取样以 CFU/g 为单位报告,体积取样以 CFU/mL 为单位报告,报告或分别报告霉菌和 / 或酵母数。
马铃薯葡萄糖琼脂 PDA( 含氯霉素)验证
1. 产品用途:供霉菌和酵母的计数、分离和培养用。
2. 检验原理:马铃薯浸出粉有助于各种霉菌的生长;葡萄糖提供能源;琼脂是培养基的凝固剂;氯霉素可抑制细菌的生长。
3. 马铃葡萄糖琼脂 PDA( 含氯霉素 ) 验证数据
| 样品名称 |
质控菌株 |
厂家 |
待测培养基计数 |
参比培养基计数(TSA) |
生长率(或特征) |
评定标准 |
结果判定 |
马铃薯 葡萄糖 琼脂 PDA ( 含氯霉素) |
酿酒酵母 ATCC9763 |
逗点 |
147 |
162 |
PR=0.9 |
PR≥0.7 |
符合 |
| L 品牌 |
133 |
| PR=0.8 |
符合 |
| H 品牌 |
103 |
PR=0.6 |
不符合 |
黑曲霉 ATCC16404 |
逗点 |
55 |
54 |
PR=1 |
PR≥0.7 |
符合 |
| L 品牌 |
65 |
PR=1.2 |
符合 |
| H 品牌 |
34 |
PR=0.6 |
不符合 |
| 大肠埃希氏菌 ATCC25922 |
逗点 |
/ |
/ |
G=0 |
G≤1 |
符合 |
| 符合 |
| L 品牌 |
/ |
/ |
G=0 |
| H 品牌 |
/ |
/ |
G=0 |
符合 |
金黄色 葡萄球菌 ATCC6538 |
逗点 |
/ |
/ |
G=0 |
G≤1 |
符合 |
| L 品牌 |
/ |
/ |
G=0 |
符合 |
| H 品牌 |
/ |
/ |
G=0 |
符合 |
1. 酿酒酵母 ATCC9763 在马铃薯葡萄糖琼脂 PDA( 含氯霉素)板上的菌落特征:菌落奶油色; 2. 黑曲霉 ATCC16404 在马铃薯葡萄糖琼脂 PDA( 含氯霉素)板上的菌落特征:白色菌丝,黑色孢子; 3. 大肠埃希氏菌 ATCC25922 在马铃薯葡萄糖琼脂 PDA( 含氯霉素)板上的菌落特征:选择性 G≤1; 4. 金黄色葡萄球菌 ATCC6538 在马铃薯葡萄糖琼脂 PDA( 含氯霉素)板上的菌落特征:选择性 G≤1 |
4、典型特征图片:
5. 验证结果小结
1. 生长率:目标菌酿酒酵母 ATCC9763 逗点、L 品牌均满足国标 PR≥0.7 的要求,H 品牌 PR=0.6 不满足国标 PR≥0.7 的要求;黑曲霉 ATCC16404,逗点、L 品牌、满足国标 PR≥0.7 的要求,H 品牌不满足国标 PR≥0.7 的要求 , 逗点、H 品牌、L 品牌都有产白色菌丝,黑色孢子,其中逗点黑色孢子生长较少,现象不明显;H 品牌、L 品牌黑色孢子生长良好,现象明显。
2. 选择性:大肠埃希氏菌 ATCC25922、金黄色葡萄球菌 ATCC6538 ,逗点、L 品牌、H 品牌均满足国标 G≤1 的要求。
3. 感观:逗点、L 品牌、H 品牌外观颜色无明显差异。
孟加拉红(虎红)琼脂验证
1. 产品用途:供霉菌和酵母的计数、分离和培养用。
2. 检验原理:蛋白胨提供碳源和氮源;葡萄糖提供能源;磷酸二氢钾为缓冲剂;硫酸镁提供必须的微量元素;琼脂是培养基的凝固剂;氯霉素可抑制细菌的生长;孟加拉红作为选择性抑菌剂可抑制细菌的生长,并可减缓某些霉菌因生长过快而导致菌落漫延生长。
3. 孟加拉红 ( 虎红 ) 琼脂验证数据
| 样品名称 |
质控菌株 |
厂家 |
待测培养基计数 |
参比培养基计数(TSA) |
生长率(或特征) |
评定标准 |
结果判定 |
孟加拉红 (虎红) 琼脂 |
酿酒酵母 ATCC9763 |
逗点 |
142 |
162 |
PR=0.9 |
PR≥0.7 |
符合 |
| L 品牌 |
72 |
| PR=0.4 |
不符合 |
| H 品牌 |
136 |
PR=0.8 |
符合 |
黑曲霉 ATCC16404 |
逗点 |
84 |
55 |
PR=1.6 |
PR≥0.7 |
符合 |
| L 品牌 |
94 |
PR=1.7 |
符合 |
| H 品牌 |
86 |
PR=1.6 |
符合 |
| 大肠埃希氏菌 ATCC25922 |
逗点 |
/ |
/ |
G=0 |
G≤1 |
符合 |
| 符合 |
| L 品牌 |
/ |
/ |
G=0 |
| H 品牌 |
/ |
/ |
G=0 |
符合 |
金黄色 葡萄球菌 ATCC6538 |
逗点 |
/ |
/ |
G=0 |
G≤1 |
符合 |
| L 品牌 |
/ |
/ |
G=0 |
符合 |
| H 品牌 |
/ |
/ |
G=0 |
符合 |
1. 酿酒酵母 ATCC9763 在孟加拉红(虎红)琼脂板上的菌落特征:菌落奶油色; 2. 黑曲霉 ATCC16404 在孟加拉红(虎红)琼脂板上的菌落特征:白色菌丝,黑色孢子; 3. 大肠埃希氏菌 ATCC25922 在孟加拉红(虎红)琼脂板上的菌落特征:选择性 G≤1; 4. 金黄色葡萄球菌 ATCC6538 在孟加拉红(虎红)琼脂板上的菌落特征:选择性 G≤1 |
4、典型特征图片:
5. 验证结果小结
1. 生长率:目标菌酿酒酵母 ATCC9763 逗点、H 品牌均满足国标 PR≥0.7 的要求,L 品牌 PR=0.4 不满足国标 PR≥0.7 的要求,且生长速度缓慢,菌落较小。黑曲霉 ATCC16404,逗点、L 品牌、H 品牌均满足国标 PR≥0.7 的要求,逗点、H 品牌、L 品牌都有产白色菌丝,黑色孢子,其中逗点、H 品牌黑色孢子生长现象明显。
2. 选择性:大肠埃希氏菌 ATCC25922、金黄色葡萄球菌 ATCC6538 ,逗点、L 品牌、H 品牌均满足国标 G≤1 的要求。
3. 感观:逗点、L 品牌颜色为紫红色,颜色较深;H 品牌颜色为粉红色,颜色较浅。